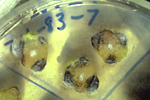

Verticillium wilt
Verticillium dahliae and Verticillium albo-atrum
Over 400 plant species including herbaceous annuals (ex. –potato), perennials (ex. –peppermint), and woody species (ex. –maple). This list is expanding with the addition of new hosts succumbing to the pathogen.
Note: Several species of Verticillium cause symptoms of Verticillium wilt, but Verticillium dahliae and V. albo-atrum cause economic losses in crops in temperate regions of the world and hence are the most studied species. The disease cycle of both species is similar in most aspects except that V. dahliae produces microsclerotia and V. albo-atrum produces melanized mycelia for survival between crops. Therefore, only V. dahliae is emphasized in this lesson.

Unilateral leaf necrosis and wilt in potato.
Verticillium spp. have a wide host range, including herbaceous annuals and perennials and woody perennials. Verticillium wilt is problematic in temperate areas of the world, especially in irrigated regions. The pathogens can persist in soil for many years in the absence of a susceptible crop. Infection is through the roots, and management of the disease is difficult.
Symptoms and Signs
Symptoms vary somewhat among hosts, and none is absolutely diagnostic. Premature foliar chlorosis and necrosis and vascular discoloration in stems and roots, however, are characteristic of all hosts. Symptoms of wilting are most evident on warm, sunny days.
Symptoms, Potato
Foliar symptoms first appear as chlorosis and necrosis beginning in the lower leaves. On warm, sunny days, leaves may appear limp and flaccid. Sometimes symptoms occur on only one side of the leaf or the plant (Figure 1). In severely diseased plants, medium-tan discoloration of the vascular tissue is evident (Figure 2), and the plants may be stunted. Tubers of some cultivars may develop a light brown discoloration of the vascular ring, although other factors may cause this symptom. Tuber yield is reduced because of the decreased rate of photosynthesis and premature death of foliage. The optimum temperature range for potato growth is 18-20° C (64-68° F). When the temperature rises above 20° C (68° F), plant stress increases and symptoms of Verticillium wilt are more severe.

Figure 1 |

Figure 2 |
Symptoms, Peppermint
Symptoms first appear in the foliage at the top of the plant (Figure 3). Symptomatic upper leaves are sickle-shaped and initially chlorotic or red, soon becoming necrotic (Figure 4). Premature defoliation and death of the plant can result. Vascular discoloration in stems and roots may be observed and diseased plants are often stunted. Rhizomes produced in the fall are weakened and may be killed in the winter.

Figure 3 |

Figure 4 |
Symptoms, Maple
In woody perennials such as maple, symptomatic leaves are chlorotic and necrotic, dry, and smaller than normal. Symptoms often occur on only one or several branches (Figure 5). The sapwood is brown in discoloration (Figure 6). Diseased trees may have sparse foliage, branch dieback, buds which fail to open in the spring, and/or fall coloration that develops a few weeks preceding normal autumn coloration. Infected trees may die; however, sometimes trees can be saved if symptomatic branches are pruned.

Figure 5 |

Figure 6 |
Diagnosis
Since fungal structures are not visible on most diseased specimens, confirmation of Verticillium wilt requires the use of simple laboratory techniques. Small, thin pieces of infected vascular tissue can be placed onto a culture medium such as streptomycin water agar or Sorensen's NP-10 medium and incubated for 4 days. When the fungus grows out of the vascular tissue it can be examined microscopically (Figure 7). This technique is commonly used in plant disease clinics.
Figure 7 |
Signs
Small, black, thick walled resting structures, called microsclerotia, are formed in the dying tissue (Figure 8) or live tissue (Figure 9) and are frequently visible with a hand lens. Even though microsclerotia form on senescent tissues in most hosts, they are readily apparent in some hosts on live tissue as well.

Figure 8 |

Figure 9 |
Pathogen Biology
Pathogen morphology
Verticillium belongs to the fungal class Deuteromycetes (Fungi Imperfecti), a group of fungi which do not have a known sexual stage. The vegetative mycelium is hyaline, septate, and multinucleate. The nuclei are haploid. Conidia are ovoid or ellipsoid and usually single-celled. They are borne on phialides, which are specialized hyphae produced in a whorl around each conidiophore. Each phialide carries a mass of conidia (Figure 10 ). Verticillium is named for this "verticillate" (=whorled) arrangement of the phialides on the conidiophore.

Figure 10 |
As the diseased plant senesces, the fungus becomes saprophytic and colonizes the dying tissues. During colonization, the fungus forms microsclerotia, which are masses of melanized hyphae.
Host specificity
Within the species Verticillium dahliae strains with varying morphology and pathogenicity have been identified. Strains have been classified into several vegetative compatibility groups (VCG). Each VCG includes those isolates which can anastamose (Figure 11) and form stable heterokaryons Anastomosis is the fusion of two adjacent fungal hyphae, resulting in the exchange of cellular contents. Heterokaryons, products of anastomosis, are mycelia containing the nuclei from each of two genetically different parent mycelia. Since Verticillium does not exchange genetic information through sexual reproduction, anastomosis is the only means by which genetic diversity increases within the species.

Figure 11 |
Each VCG is somewhat specific to a host plant or related group of hosts and may or may not be as virulent on other hosts (Table 1). For example, VCG 2 is very virulent on peppermint and less virulent on watermelon. VCG 4 is virulent on potato and related Solanaceous species, but less virulent on maple and peppermint.
Table 1. Vegetative compatibility groups of Verticillium dahliae associated with maple, peppermint, and potato
|
Plant host |
VCG |
|
Maple |
1 |
|
Peppermint |
2 |
|
Potato |
4 |
Disease Cycle and Epidemiology

Disease process
Verticillium wilt is favored by moist soils and a temperature range of 21-27° C (70-81° F). Microsclerotia are stimulated to germinate by root exudates of both host and non-host plants (Figure 12). The fungus penetrates a root of a susceptible plant in the region of elongation and the cortex is colonized. From the cortex, the hyphae invade the xylem vessels where conidia are formed (Figure 13). Vascular colonization occurs as conidia are drawn up into the plant along with water. Due to fungal material and host reaction products, the vascular system becomes plugged, preventing water from reaching upper parts of the plant. Leaves and stems deprived of water soon begin to exhibit symptoms of wilting and foliar chlorosis. As the diseased plant senesceces, the fungus produces microsclerotia which are released into the soil with the decomposition of plant material. The fungus survives for many years in this dormant form or as mycelium or conidia in the vascular system of perennial plants.

Figure 12 |

Figure 13 |
Spread of the pathogen
The transport of infected planting stock can move the pathogen long distances. In bare root or vegetatively propagated plants such as ornamentals or peppermint, a nursery may spread the fungus by selling non-symptomatic, but infected, planting stock. Similarly, Verticillium can be spread in infected potato seed tubers. Once established in a field or landscape, spread of the pathogen occurs primarily by soil cultivation and movement of soil by wind or water. Verticillium propagules occur in highest concentration in the top 30 cm (12 inches) of the soil profile, but they have been recovered from depths as low as 41 cm (16 inches). Inoculum densities and disease severity tend to increase from year to year when susceptible crops are planted.
Nematode/Verticillium interactions
Symptoms of Verticillium wilt of potato and peppermint are often more severe in fields infested with the root-lesion nematode, Pratylenchus penetrans. This nematode may increase the severity of the disease by altering the host physiology, thus making the plant more susceptible to damage. Symptoms may develop even when population densities of Verticillium and P. penetrans individually are too low to cause significant disease.
Disease Management
Preplant management options
Site selection: Most of the land now cropped to potatoes and peppermint is infested with Verticillium. In landscapes where susceptible plants (Table 2) have been grown previously, the soil can be infested. Even in settings where non-susceptible hosts such as wheat, barley, and legumes, have been grown, Verticillium has been isolated from the roots, indicating that these nonhosts may serve as a reservoir of the pathogen in some environments. Therefore, consideration must be given to the cropping history and Verticillium wilt history of the site. Laboratory tests can estimate the population size of Verticillium in the soil.
Table 2. Plants resistant or susceptible to Verticillium wilt
Resistant or Immune |
Susceptible |
Trees |
| beech, birch, conifers (all), crabapple, dogwood, eucalyptus, hackberry, hawthorn, honey locust, hornbeam, katsura tree, mountain ash, mulberry, plane tree, poplar, sweetgum, sycamore, willow |
ash, black locust, box elder, camphor tree, carob, carrotwood, elm, catalpa, cork tree, elder, elm, flannel bush, fringe tree, golden-rain, tree, horse chestnut, Japanese, pagoda tree, Kentucky, coffee tree, linden, magnolia, maple, oak, peppertree, persimmon, Prunus sp., redbud, Russian olive, sassafras, serviceberry, smoke tree, tree of heaven, tupelo, tulip tree, walnut, yellowwood |
Shrubs |
| arborvitaejuniper |
fuchsia, heather, lilac, privet, rose, sumac, Viburnum sp. |
Vegetables |
| asparagus, beanpea |
cabbage, celery, cucumber, eggplant, lettuce, melons, pepper, potato, pumpkin, radish, rhubarb, tomato |
Flowers |
| African violet, ageratum, baby’s breath, hollyhock, periwinkle, primrose, zinnia, |
aster, begonia, carnation, chrysanthemum, dahlia, geranium, impatiens, peony, petunia, snapdragon, sunflower |
Fruit |
| apple, pear |
barberry, blackberry, black raspberry, grape, Prunus sp., raspberry, Ribes sp., strawberry, watermelon |
Weeds |
| grass, monocots (all) |
dandelion, groundsel, lambsquarters, nightshade, pigweed, sagebrush,shepardspurse, velvetleaf |
Field crops |
| corn, monocots (all), |
alfalfa, clover, cotton, hops, mint, rapeseed, safflower |
Miscellaneous |
| cacti, ferns |
|
|
Reference: McCain, A.H., R.D. Raabe, and S. Wilhelm. 1981. Plants Resistant to or Susceptible to Verticillium Wilt. University of California Leaflet 2703. |
Crop rotation: Crop rotation should be viewed as a preventative, not a curative disease management option for two reasons. First, the host range of Verticillium is very wide. Second, the survival structure, the microsclerotium, persists in soil for a long time, even in the absence of a susceptible host. Therefore, rotation programs should be initiated early, before inoculum builds up to high levels in the soil. Populations of the pathogen decline very slowly through mortality over time. Fallowing a field (leaving it uncropped and weed-free during the growing seasons) or planting non-susceptible crops for several consecutive seasons do not lead to significant reductions in the populations of microsclerotia. Rotation in general is a less effective disease management tool compared to other methods, but is generally a good management practice for multiple reasons. Recent studies, however, have demonstrated that specific rotations such as those with broccoli lead to significant, long-term reductions in the populations of microsclerotia. Hence, attempts to identify hosts that are not only non-hosts of Verticillium spp., but also bring about significant reductions in microsclerotia in soil, that are compatible with production practices in a given area are urgently needed.
Chemical fumigation: Application of soil fumigants is an effective, but expensive control tactic. Fumigants are applied through either shank injectors (Figure 14) or irrigation systems in either the fall or the spring. When injected, the soil is sometimes covered with plastic to prevent volatilization of the fumigant (Figure 15). Depending upon the chemical, rate, and environmental conditions at time of application, reduction in soil populations have ranged from 85-95%. Fumigation rates need to be high when soil populations of Verticillium are large or when populations need to be reduced for multiyears, as with perennial crops such as peppermint and maple. Some soil fumigants can be detrimental to the environment, and some of these fumigants will no longer be registered for use in the next few years.

Figure 14 |

Figure 15 |
Cultivars: Resistant or partially resistant cultivars of some susceptible plant species, including potato, peppermint, and maple, are available (Table 3). In the presence of very high Verticillium soil populations, however, even resistant cultivars may exhibit symptoms of Verticillium wilt.
Table 3. A selection of Verticillium resistant potato, peppermint, and Norway maple cultivars
|
Potato |
Peppermint |
Norway maple |
|
Resistant
Abnaki, Century Russet, Desiree, Elba, Gemchip, Ranger Russet, Reddale, Rideau, Russette, Targhee |
Moderately resistant
Allegany, Atlantic, Centennial, Russet, Frontier Russet, Hampton, Katahdin, Maine Chip, Monona, Norchip, Norking Russet, Portage, Prestile, Russet Burbank, Russet Nugget |
Partially resistant
Todd’s Mitcham, Murray Mitcham, Roberts Mitcham |
Tolerant
Jade Glen, Parkway |
Pathogen-free planting stock: Species which are planted from bare-root stock or seedlings should be obtained from Verticillium wilt-free nurseries. In Oregon, a certification program is in place for ensuring Verticillium-free peppermint stock. Potatoes are not certified for this disease.
Management during the season
Fertilization: Applying optimal rates of nitrogen and phosphorus reduces the severity of Verticillium wilt symptoms in some plant species. Optimal soil fertility helps to produce plants which may be more resistant to infection by Verticillium.
Irrigation: Limiting the amount of water applied to the field can reduce severity of the disease in some plant species, such as potato. Overwatering, especially early in the growing season, results in increased infection and, thus, increased disease severity.
Management after harvest
Propane flaming: High temperatures are lethal to Verticillium propagules. Because microsclerotia reside within the crop residue, flaming crop residue at the end of a growing season reduces the amount of inoculum returned to the soil. Following peppermint harvest in the fall, propane torches are pulled behind a tractor to flame the crop refuse (Figure 16). The effect on the disease is to slow down the rate of inoculum increase in these fields.

Figure 16 |
Pruning: In woody host plants, pruning of symptomatic limbs to remove all discolored sapwood, followed by burning, has prolonged the life expectancy of some trees.
Significance
Verticillium has a wide host range; over 200 dicotyledonous species, including herbaceous annuals and perennials and woody perennials are susceptible to this fungal pathogen. The disease, Verticillium wilt, is problematic in temperate areas of the world, especially in irrigated regions. There are no curative measures once a plant is infected. Planting pathogen-free stock into soil free of the pathogen is the best way to avoid the disease.
Potato
Verticillium wilt of potato occurs wherever potatoes as grown. It is most severe in irrigated fields, especially in hot climates. Yields of potatoes grown in Verticillium infested soils may be 30-50% lower than yields on noninfested land. In some varieties, the discoloration of the vascular tissue in tubers results in tuber quality reduction.
Peppermint
The peppermint industry was centered in the midwestern U.S. in the mid- to late-1800's. Peppermint acreage has increased in the western states since the 1930's, as Verticillium wilt intensified in the midwest. Oregon has claimed half the national acreage since the 1960's, but the spread of Verticillium through the originally planted regions of Oregon, Washington, and Idaho is now forcing more acreage into new areas of these same states and other western locations. The remaining midwest acreage is occasionally relocated to noninfested land. Peppermint is grown for the oil it yields. Oil yields and stand longevity are reduced as wilt intensifies in a field.
Maple
The quality of nursery commodities, such as maple and ash trees, and flowers, like chrysanthemum and dahlia, is decreased when infected with Verticillium. Infected plants undergo premature defoliation, may be stunted or short-lived, and are undesirable in home and public landscapes. Purchase of planting stock from infested nurseries may be restricted, thus decreasing its value.
Selected References
Ben-Yephet, Y., Z.R. Frank, J.M. Malero-Vero, and J.E. DeVay. 1989. Effect of crop rotation and metham-sodium on Verticillium dahliae. Pages 543-546 in Vascular Wilt Diseases of Plants: Basic Studies and Control. Tjamos, E.C. and C.H. Beckman, (eds). Springer-Verlag, New York
Butterfield, E.J. and J.E. DeVay. 1977. Reassessment of soil assays for Verticillium dahliae. Phytopathol. 67:1073-1078.
Davis, J.R., O.C. Huisman, D.T. Westerman, S.L. Hafez, D.O. Everson, L.H. Sorensen, and A.T. Schneider. 1996. Effects of green manures on Verticillium wilt of potato. Phytopathol. 86:444-453.
Heffer, V. and R. Regan. 1995. Verticillium wilt of ash. The Digger. June: 48-49.
Hiemstra, J.A. and D.C. Harris (eds.). 1999. A Compendium of Verticillium Wilt in Tree Species. Ponsen & Looijen, Wageningen, The Netherlands. 80 pp.
Kabir, Z., R. G. Bhat, and K. V. Subbarao. 2004. Comparison of media for recovery of Verticillium dahliae from soil. Plant Dis. 88:49-55.
MacGuidwin, A.E. and D.I. Rouse. 1990. Role of Pratylenchus penetrans in the potato early dying disease of Russet Burbank potato. Phytopathol. 80:1077-1082.
McIntyre, J.L. and C.E. Horner. 1973. Inactivation of Verticillium dahliae in peppermint stems by propane gas flaming. Phytopathol. 63:172-173.
Powelson, M.L. and R.C. Rowe. 1993. Biology and management of early dying of potatoes. Ann. Rev. of Phytopathol. 31:111-126.
Rowe, R.C. 1995. Recent progress in understanding relationships between Verticillium species and subspecific groups. Phytoparasitica 23:31-38.
Rowe, R.C., J.R. Davis, M.L. Powelson, and D.I. Rouse. 1987. Potato early dying: Causal agents and management strategies. Plant Dis. 71:482-489.
Rowe, R.C. and M.L. Powelson. 2002. Potato early dying: management challenges in a changing production environment. Plant Dis. 86:1184-1193.
Schnathorst, W.C. 1981. Life cycle and epidemiology of Verticillium. Pages 81-111 in: Fungal Wilt Diseases of Plants. ed. E. Mace, A.A. Bell, C.H. Beckman (eds). Academic Press, San Fransisco
Schreiber, L.R. and J.S. Mayer. 1992. Seasonal variations in susceptibility and in internal inoculum densities in maple species inoculated with Verticillium dahliae. Plant Dis. 76:184-187.
Smith, L.D. and D. Neely. 1979. Relative susceptibility of tree species to Verticillium dahliae. Plant Disease Reporter 63:328-332.
Subbarao, K. V., J. C. Hubbard, and S. T. Koike. 1999. Evaluation of broccoli residue incorporation into field soil for Verticillium wilt control in cauliflower. Plant Dis. 83:124-129.
Xiao, C. L., K. V. Subbarao, K. F. Schulbach, and S. T. Koike. 1998. Effects of crop rotation and irrigation on Verticillium dahliae microsclerotia in soil and wilt in cauliflower. Phytopathology 88:1046-1055.
